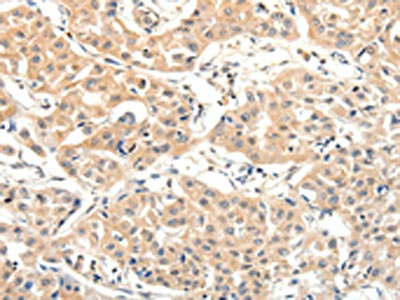

SLC27A1 Antibody
-
中文名稱:SLC27A1兔多克隆抗體
-
貨號:CSB-PA232605
-
規格:¥1100
-
圖片:
-
The image on the left is immunohistochemistry of paraffin-embedded Human liver cancer tissue using CSB-PA232605(SLC27A1 Antibody) at dilution 1/40, on the right is treated with synthetic peptide. (Original magnification: ×200)
-
The image on the left is immunohistochemistry of paraffin-embedded Human lung cancer tissue using CSB-PA232605(SLC27A1 Antibody) at dilution 1/40, on the right is treated with synthetic peptide. (Original magnification: ×200)
-
-
其他:
產品詳情
-
Uniprot No.:
-
基因名:
-
別名:SLC27A1 antibody; ACSVL5 antibody; FATP1Long-chain fatty acid transport protein 1 antibody; FATP-1 antibody; Fatty acid transport protein 1 antibody; EC 6.2.1.- antibody; Solute carrier family 27 member 1 antibody
-
宿主:Rabbit
-
反應種屬:Human
-
免疫原:Synthetic peptide of Human SLC27A1
-
免疫原種屬:Homo sapiens (Human)
-
標記方式:Non-conjugated
-
抗體亞型:IgG
-
純化方式:Antigen affinity purification
-
濃度:It differs from different batches. Please contact us to confirm it.
-
保存緩沖液:-20°C, pH7.4 PBS, 0.05% NaN3, 40% Glycerol
-
產品提供形式:Liquid
-
應用范圍:ELISA,IHC
-
推薦稀釋比:
Application Recommended Dilution ELISA 1:2000-1:5000 IHC 1:50-1:200 -
Protocols:
-
儲存條件:Upon receipt, store at -20°C or -80°C. Avoid repeated freeze.
-
貨期:Basically, we can dispatch the products out in 1-3 working days after receiving your orders. Delivery time maybe differs from different purchasing way or location, please kindly consult your local distributors for specific delivery time.
-
用途:For Research Use Only. Not for use in diagnostic or therapeutic procedures.
相關產品
靶點詳情
-
功能:Mediates the ATP-dependent import of long-chain fatty acids (LCFA) into the cell by mediating their translocation at the plasma membrane. Has also an acyl-CoA ligase activity for long-chain and very-long-chain fatty acids. May act directly as a bona fide transporter, or alternatively, in a cytoplasmic or membrane-associated multimeric protein complex to trap and draw fatty acids towards accumulation. Plays a pivotal role in regulating available LCFA substrates from exogenous sources in tissues undergoing high levels of beta-oxidation or triglyceride synthesis. May be involved in regulation of cholesterol metabolism. Probably involved in fatty acid transport across the blood barrier.
-
基因功能參考文獻:
- Neonatal phthalate ester exposure induced placental MTs, FATP1 and HFABP mRNA expression PMID: 26867681
- Several proteins that are expressed in the epidermis have been proposed to facilitate the uptake of long-chain fatty acids (LCFA) in mammalian cells, CD36, fatty acid binding protein, and FATP. [review] PMID: 24120574
- Observational study of gene-disease association. (HuGE Navigator) PMID: 20965718
- Observational study of gene-disease association. (HuGE Navigator) PMID: 19913121
- Observational study of gene-disease association, gene-environment interaction, and pharmacogenomic / toxicogenomic. (HuGE Navigator) PMID: 20628086
- FATP1 inhibits 11-cis retinol formation via interaction with the visual cycle retinoid isomerase RPE65 and lecithin:retinol acyltransferase PMID: 20356843
- Observational study of gene-disease association and gene-gene interaction. (HuGE Navigator) PMID: 20416077
- exogenously supplied fatty acids are preferentially channeled by an FATP1-linked mechanism into the TG biosynthetic pathway; such internalized lipids downregulate de novo sphingomyelin and cholesterol metabolism in growing 293 cells PMID: 12235169
- FATP1 might play a role in post-prandial lipid metabolism and development of cardiovascular disease. PMID: 12818409
- FATP1 stimulated transport and consumption of palmitate and oleate, which they channeled away from complete oxidation and toward TAG synthesis. PMID: 15897321
- These data reveals the localization and points to a regulatory function of FATP1 in myotube mitochondria. PMID: 19361580
- Observational study of gene-disease association. (HuGE Navigator) PMID: 18660489
- Observational study of gene-disease association. (HuGE Navigator) PMID: 12818409
- Observational study of gene-disease association. (HuGE Navigator) PMID: 15978856
顯示更多
收起更多
-
亞細胞定位:Cell membrane; Single-pass membrane protein. Endomembrane system; Single-pass membrane protein. Cytoplasm.
-
蛋白家族:ATP-dependent AMP-binding enzyme family
-
組織特異性:Highest levels of expression are detected in muscle and adipose tissue small, intermediate levels in small intestine, and barely detectable in liver. Expressed in brain gray matter.
-
數據庫鏈接:
Most popular with customers
-
-
YWHAB Recombinant Monoclonal Antibody
Applications: ELISA, WB, IHC, IF, FC
Species Reactivity: Human, Mouse, Rat
-
Phospho-YAP1 (S127) Recombinant Monoclonal Antibody
Applications: ELISA, WB, IHC
Species Reactivity: Human
-
-
-
-
-